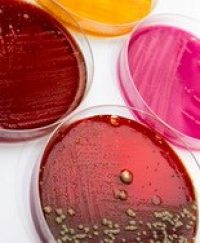
Piastre batteri resistenza

Da “DoctorNews” del 20 maggio 2016
Se non verranno prese misure adeguate, entro il 2050 la resistenza agli antibiotici potrebbe rappresentare una causa di morte più pericolosa del cancro, portando alla morte di 10 milioni persone ogni anno nel mondo. La minacciosa previsione è contenuta in un rapporto (Review on antimicrobial resistance) pubblicato oggi che è stato commissionato dal Governo britannico alle autorità sanitarie inglesi. Una “apocalisse farmacologica” che, in realtà, potrebbe essere più vicina di quanto si possa immaginare. Secondo Sally Davies, Chief medical officer inglese, già oggi, ogni anno, 50.000 persone perdono la vita in Europa e negli Stati Uniti a causa dell’antibioticoresistenza. Un articolo del giornale inglese Guardian che si è occupato di questo argomento ha previsto che malattie infettive come la tubercolosi e la gonorrea possano tornare a essere pericolose come nell’era pre-antibiotici. Viene infatti riportato che, già oggi, nel mondo vengono registrati 480.000 casi di tubercolosi multiresistenti. Infezioni che provocano ogni anno 190.000 decessi.
David Cameron, primo ministro inglese non ha usato mezzi termini commentando il contenuto del rapporto: «Se dovessimo fallire nel contrastare questa minaccia» ha affermato «dovremo prepararci ad affrontare uno scenario quasi impensabile in cui gli antibiotici non hanno più effetto. Sarebbe un ritorno al medioevo della medicina». «Abbiamo raggiunto un punto critico» ha aggiunto Davies. «Dobbiamo agire subito, e a livello globale, per porre un freno alla caduta di efficacia degli antibiotici». Il fenomeno dell’antibioticoresistenza ha avuto origine, tra le altre cose, nell’uso eccessivo e spesso scorretto e incompleto di questi farmaci. La situazione in cui ci si trova oggi ci obbliga a un cambio di prospettiva. È indispensabile infatti che sia i medici che i pazienti imparino a usare gli antibiotici con appropriatezza.
Il riferimento è a un uso mirato delle terapie antibiotiche che devono essere prescritte solo dopo essersi accertati della sensibilità del patogeno da trattare alla specifica molecola prescritta. I pazienti, dal canto loro, devono prendere consapevolezza delle esatte indicazioni degli antibiotici, seguire con scrupolo le terapie prescritte e non usarli in autonomia.
Gianluca Casponi